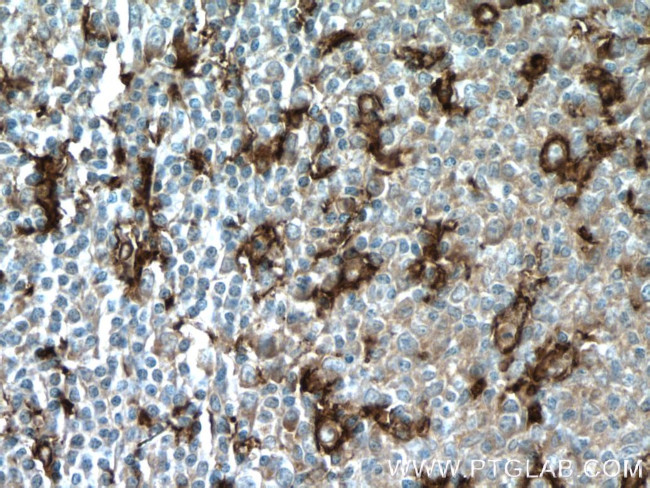
CD11c/Integrin alpha X Antibody in Immunohistochemistry (Paraffin) (IHC (P))
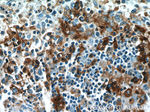
CD11c/Integrin alpha X Antibody in Immunohistochemistry (Paraffin) (IHC (P))

Search
Proteintech
CD11c/Integrin alpha X Polyclonal Antibody
{{$productOrderCtrl.translations['antibody.pdp.commerceCard.promotion.promotions']}}
{{$productOrderCtrl.translations['antibody.pdp.commerceCard.promotion.viewpromo']}}
{{$productOrderCtrl.translations['antibody.pdp.commerceCard.promotion.promocode']}}: {{promo.promoCode}} {{promo.promoTitle}} {{promo.promoDescription}}. {{$productOrderCtrl.translations['antibody.pdp.commerceCard.promotion.learnmore']}}
产品信息
17342-1-AP
种属反应
已发表种属
宿主/亚型
分类
类型
抗原
偶联物
形式
浓度
规格
纯化类型
保存液
内含物
保存条件
运输条件
产品详细信息
Immunogen sequence: NLDTEELTA FRVDSAGFGD SVVQYANSWV VVGAPQKITA ANQTGGLYQC GYSTGACEPI GLQVPPEAVN MSLGLSLAST TSPSQLLACG PTVHHECGRN MYLTGLCFLL GPTQLTQRLP VSRQECPRQE QDIVFLIDGS GSISSRNFAT MMNFVRAVIS QFQRPSTQFS LMQFSNKFQT HFTFEEFRRS SNPLSLLASV HQLQGFTYTA TAIQNVVHRL FHASYGARRD AAKILIVITD GKKEGDSLDY KDVIPMADAA GIIRYAIGVG LAFQNRNSWK ELNDIASKPS QEHIFKVEDF DALKDIQNQL KEKIFAIEGT ETTSSSSFEL EMA (21-352 aa encoded by BC038237)
靶标信息
CD11, along with CD18, form a heterodimer adhesion molecule. In particular, CD11 is composed of CD11a, CD11b and CD11c. CD11a is a leukocyte marker that is expressed in B and T lymphocytes, macrophages, monocytes, neutrophils, basophils and eosinophils. CD11b is primarily expressed by monocytes, macrophages, natural killer cells, some B and T-cells, and granulocytes. CD11c is expressed in monocytes, macrophages, natural killer cells, some granulocytes and less so in a subset of lymphocytes.
仅用于科研。不用于诊断过程。未经明确授权不得转售。
生物信息学
蛋白别名: CD11 antigen-like family member C; CD11c; complement component 3 receptor 4 subunit; integrin alpha X; Integrin alpha-X; integrin, alpha X (antigen CD11C (p150), alpha polypeptide); integrin, alpha X (complement component 3 receptor 4 subunit); integrin; protein p150,95; Leu M5; leu M5, alpha subunit; Leukocyte adhesion glycoprotein p150,95 alpha chain; Leukocyte adhesion receptor p150,95; leukocyte surface antigen p150,95, alpha subunit; myeloid membrane antigen, alpha subunit; p150 95 integrin alpha chain; unnamed protein product
基因别名: CD11C; ITGAX; SLEB6
UniProt ID: (Human) P20702
Entrez Gene ID: (Human) 3687